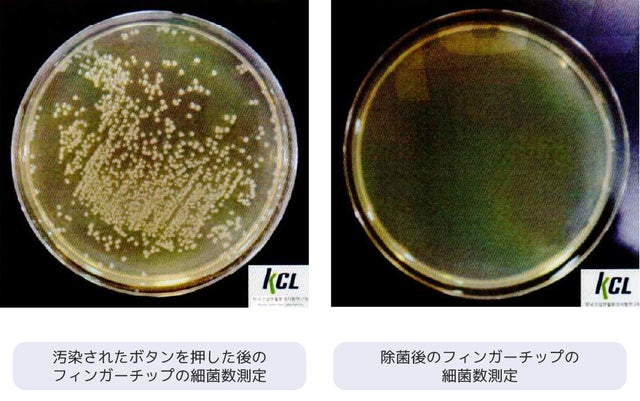

プロジェクト実行者
ストーリー
- スマートフォン、タブレット、タッチパネルの画面にタッチ可能。
- フィンガーチップを入れると UV-C自動除菌モード!
- USB タイプCケーブルで簡単に充電ができます。

玄関を出た瞬間から、見えない細菌やウイルスの不安がある今、
どれだけ手をよく洗っても避けることができないものがあります。
日常生活で何気なく触ってしまう、細菌


マンションのオートロック、スマートフォン、タブレット、ATM、自動ドアの開閉ボタン、自動販売機、エレベーターのボタン…
不特定多数の人たちが触れる共有の場所!
共有の場所のボタンには数多くの細菌やウイルスが存在します。
そしていつ、私たちの手がそれらに触れているのかも分かりません

あっという間に私たちの日常を脅かすウイルスや細菌、
UV-Cシールドフィンガーが代わりに押します!
何かを押さないといけない瞬間、そっと取り出してください。



日常生活で多くの場所に存在するウイルスや細菌、出来るだけ接触しないように製作した「AalokロックUV-Cシールドフィンガー」はエレベーターのボタン、自動販売機だけでなく「スマートフォン、ATM画面」等のタッチスクリーン、食堂の券売機、駐車場の精算機など多様な場所で活躍します。


• 指で顔をよく触ってしまうお子様
• 免疫力が低下しやすい高齢者
• 毎日多くの人たちに会う方
• 日頃、衛生に気を遣ってらっしゃる方
• 自動販売機でよく飲み物などを買われる方
• オートロック機能があるマンションにお住まいの方



あらゆる場所で出会うすべてのタッチパネルやボタン、UV-Cシールドフィンガーが代わりに押します。

いつも使用しているスマートフォンやタブレットの画面はどれくらい汚れているでしょうか?
スマートフォンの画面はトイレの便座の5倍もの細菌が存在するといわれています。
どれだけ手を洗っても1日に何回も触らなければいけないスマートフォン、
UV-Cシールドフィンガーは現代人のライフスタイルを反映したスマートな除菌グッズです。


使用後、レバーだけおろしてください。
本体の中で約1分間自動にフィンガーチップの除菌を開始し、
各種の細菌、ウイルスを確実に避けることができます。

除菌時は本体の後部にブルーライトが点き、除菌中であることが一目で確認できます。

各種細菌とウイルスを消滅させることができる環境に優しい紫外線、UV-C!

UVは紫外線のことです。
紫外線は 波長別に315~400nmの「UV-A」、280~315nmの「UV-B」、100~280nmの「 UV-C 」の3種類に分類されます。このうち最もエネルギーが高く、強い除菌力持つのがUV-Cで、ウイルスを除去することができます。
現在、UV-Cは空港、地下鉄、病院などで多く使用されており、その効果は立証されています。

[直接触れないから経済的]

また、一日平均10回使用されていたジェルをUV-Cシールドフィンガーに替えるとコストの削減にもつながります。

出す時はそっと! 開いて、引っ込める時はピタッ!と 閉じるフィンガーヘッド。

フィンガーヘッドのカバーで皮膚や目がUV-C LEDがに当たらないよう工夫しました。また、フィンガーチップの保護や、外部のほこりからもしっかり守ってくれ
快適に長く使うことができます。


いつでもどこでもすぐ利用できるUV-Cシールドフィンガー。

小さくて軽いので、バックやポケットに入て持ち運びやすいです。
また、UV-Cシールドフィンガーは様々なストラップに装着可能です。
カラビナやストラップなどで本体の先に繋いで首にかけるとすぐに使うことが
できます。


持ちやすいボディとなめらかな素材を使用し、
指にピタッとはまるグリップ感を実現しました。

•Step 1 スライドボタンを上にあげるとヘッドカバーが開いてフィンガーチップが前に出ます。
•Step 2 押すことが必要なすべての場所に指の代わりに使用してください。(ボタンを押したまま使用)
•Step 3 レバーを下げるとフィンガーチップが本体に戻り、ヘッドカバーが閉じます。その後、自動除菌モードになります。





※UV-Cシールドフィンガーは USB タイプCケーブルで充電可能です。
※LEDのバッテリーが無くなってもタッチヘッドはそのまま使用可能です。
※ご使用環境、または充電環境により使用回数とフル充電までの時間は個人差があります。ご了承ください。
※2時間のフル充電後、1時間使用が可能です。


※UV-C LEDに衝撃を与えたり、手で直接触ったりしないでください。

【リターン詳細】
• UV-Cシールドフィンガー本体
• 充電ケーブル(C-TYPE)
• 手首ストラップ
• 取り扱い説明書
※ストラップはデザイン変更があるため、活動レポートにてお知らせします。

Q. 充電時間はどのくらいですか?
A フル充電までには約2時間かかります。
Q. 子供が使っても大丈夫ですか?
A. はい。お子様もご使用可能です。
Q フィンガーチップが収納後、除菌の時間はどれくらいかかりますか?
A. 約60秒かかります。
Q バッテリーがない時に除菌は可能ですか?
A いいえ、充電した状態の時だけフィンガーチップがUV-Cにより除菌されます。


1970年に設立しましたパーカースは専門的なLED技術を基に、ヘルスケア&ビューティー製品を開発するため傘下ブランドのAalokを設立しました。
これまでLEDセラピーは医療専門家たちの間だけで使用可能な領域でした。
しかし、弊社は一般人も気軽にご利用いただける「LEDセラピー」、ホームケア機器を研究、開発してきました。
今回、生活必需品となった除菌グッズをよりスマートに使っていただくため、
除菌も欠かせないスマートな除菌グッズです。たくさんのご支援と応援の程、よろしくお願いします。
リスク&チャレンジ
※製品は既に完成していますが、生産状況・天候・配送問題などで、輸送が遅延する可能性がございますので、ご留意ください。 ※ご支援の数が想定を上回った場合、製造工程上の都合等により出荷時期が遅れる場合がございます。 ※並⾏輸⼊品が発⽣する可能性があります。個⼈輸⼊及び販路によっては防ぐことができない可能性がありますのでご了解ください。
サポーターからの応援コメント
文章のトップに戻る
応援購入する
このプロジェクトはAll in型です。目標金額の達成に関わらず、プロジェクト終了日の2021年05月08日までに支払いを完了した時点で購入が成立します。
【超早割】タッチして除菌まで!UV-Cシールドフィンガー× 1個

5,520円(税込)
・Aalok UV-Cシールドフィンガー× 1個
【一般販売予定価格6,900円の20%OFF】
※ご注文状況、使用部材の供給状況、製造工程上の都合等により出荷時期が遅れる場合があります。 ※皆様のご支援により量産効率が向上した場合、正規販売価格が販売予定価格より下がる可能性もございます。
【早割】タッチして除菌まで!UV-Cシールドフィンガー× 1個

6,210円(税込)
・Aalok UV-Cシールドフィンガー× 1個
【一般販売予定価格6,900円の10%OFF】
※ご注文状況、使用部材の供給状況、製造工程上の都合等により出荷時期が遅れる場合があります。 ※皆様のご支援により量産効率が向上した場合、正規販売価格が販売予定価格より下がる可能性もございます。
【超早割】タッチして除菌まで!UV-Cシールドフィンガー× 2個

8,970円(税込)
Aalok UV-Cシールドフィンガー×2個
【一般販売予定価格13,800円の35%OFF】
※ご注文状況、使用部材の供給状況、製造工程上の都合等により出荷時期が遅れる場合があります。 ※皆様のご支援により量産効率が向上した場合、正規販売価格が販売予定価格より下がる可能性もございます。
【早割】タッチして除菌まで!UV-Cシールドフィンガー× 2個

10,350円(税込)
・Aalok UV-Cシールドフィンガー×2個
【一般販売予定価格13,800円の25%OFF】
※ご注文状況、使用部材の供給状況、製造工程上の都合等により出荷時期が遅れる場合があります。 ※皆様のご支援により量産効率が向上した場合、正規販売価格が販売予定価格より下がる可能性もございます。
「Makuake(マクアケ)」は、実行者の想いを応援購入によって実現するアタラシイものやサービスのプラットフォームです。このページは、 プロダクトカテゴリの 「タッチしてすぐ除菌!触れない生活!Aalok UV-C シールドフィンガー」プロジェクト詳細ページです。








